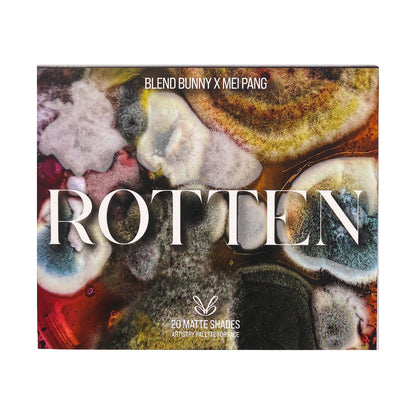

Rotten eyeshadow palette
Rotten eyeshadow palette
Created in collaboration with Mei Pang (@meicrosoft): damp, fuzzy, velvety, moist spreads of nasty but perfect shades of mold. Twenty avant-garde mattes: pale blues, moldy greens, rusty oranges, mustard yellow, the most perfect deep red, cool brown, humid black, fuzzy white, and more. A palette for those unafraid to find elegance in unconventional places.
Part of Blend Bunny Cosmetics x Mei Pang (@meicrosoft) collaboration collection.
Couldn't load pickup availability
Share

Please read before purchasing
Product details
- Magnetic pans
- Vegan and cruelty-free
- Shelf life after opening: 12 months
- Net. Wt. 25.64g / 0.90oz
- Made in China
Disclaimers and advisements
- Allergies Advisement: Please read the ingredients list carefully to ensure the item you are buying does not contain any ingredients you know you're allergic to. We do not offer refunds on cosmetics, and all sales on cosmetic items are final.
- Warning: For external use only. Keep away from children. Face pigments contain pigments which, according to US law, are not suitable for use on the eye area. Discontinue if irritation occurs.
- Variations in colour settings, lighting and qualities of phone/tablet/computer screens, etc. may cause colours to appear different in person. The actual colours may also appear different on everyone depending on the skin tone, lighting, etc. Please use our product photos as a reference guide only.
Use and storage
- ⚠️ Perform a patch test before using a new product. Please discontinue use if signs of irritation or rash appear.
- Keep your palette in a cool, dry place.
- A good primer is recommended to prevent fallout and creasing.
Ingredients
FACE PIGMENTS INGREDIENTS: (OXYGEN, SPOIL, ASPER, NEO, WHISPER, VELVET, SERPULA, VEIL, HISTO, MILDEW, STAIN, ACREMONIUM, SPORA, ORGANIC, FUSARIUM, DERMA, MARROW, DAMP, ULO, HUMID): TALC, MICA, SILICA, TRIETHOXYCAPRYLYLSILANE, ETHYLHEXYL PALMITATE, MAGNESIUM STEARATE, POLYISOBUTENE, DIMETHICONE, BIS-DIGLYCERYL POLYACYLADIPATE-2, TRIDECYL TRIMELLITATE, PHENOXYETHANOL, CAPRYLYL GLYCOL, TOCOPHERYL ACETATE, 1, 2-HEXANEDIOL, METHICONE, ETHYLHEXYLGLYCERIN.
MAY CONTAIN(+/-): TITANIUM DIOXIDE(CI 77891), IRON OXIDE BLACK(CI 77499), IRON OXIDE RED(CI 77491), IRON OXIDE YELLOW(CI 77492), D&C BLACK 2(CI 77266), D&C RED 7 CA LAKE(CI 15850), D & C RED 27 AL LAKE(CI 45410), D & C RED 6(CI 15850), FD & C YELLOW 5 AL LAKE(CI 19140), FERRIC AMMONIUM FERROCYANIDE(CI 77510), FD & C BLUE 1 AL LAKE(CI 42090), CHROMIUM OXIDE GREENS(CI 77288), ULTRAMARINES(CI 77007).
Shipping and returns
Cancellations: If you made a mistake in your order, please contact us as soon as possible. We will do our best to amend it, but there is no guarantee: Once the order is processed for shipping, we are unable to change or cancel it. Please make sure that your order is accurate.
Returns and refunds: Please be certain of your purchase, as this item is not refundable. If you have questions about a product, please contact our support team.
Returns to sender due to address inaccuracies or recipient unavailable: Such returns will incur a $20.00 CAD restocking fee and a return shipping charge.